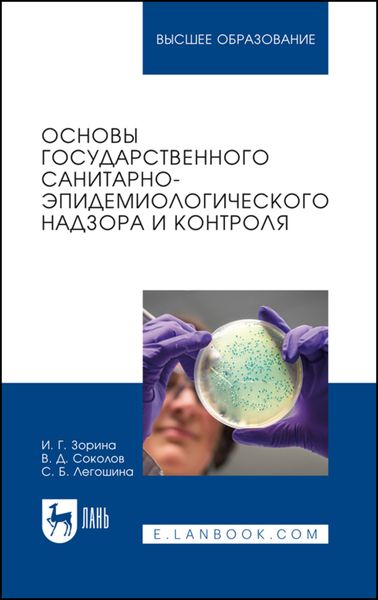
Основы государственного санитарно-эпидемиологического надзора и контроля. Учебное пособие для вузов

Книги автора «Ирина Геннадьевна Зорина»

Проведение санитарно-гигиенических и профилактических мероприятий по обеспечению безопасности среды обитания. Основы государственного санитарно-эпидемиологического надзора и контроля. Учебное пособие для вузов
Ирина Геннадьевна Зорина
Основы государственного санитарно-эпидемиологического надзора и контроля. Учебное пособие для вузов
Ирина Геннадьевна Зорина



